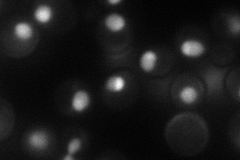
YOR077W
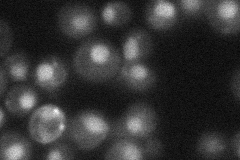
YOR077W
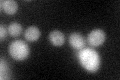
YOR077W
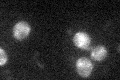
YOR077W
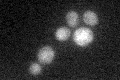
YOR077W

View description
Basic zinc-finger protein, similar to human and mouse Kin17 proteins which are chromatin-associated proteins involved in UV response and DNA replication
Localization:
Intensity:
Fold change:
Significance:
-
C’ GFP library in SD

cytosol33.44 -
N' NOP1pr-GFP in SD
nucleus,nucleolus53.606 -
N' TEF2pr-mCherry in SD

nucleus,nucleolus42.884 -
N' NATIVEpr-GFP in SD
nucleus33.9358 -
N' TEF2pr-VC and Cyto-VN in SD

cytosol30.3571 -
C’ GFP library in SD+DTT
cytosol31.90.95No -
C’ GFP library in SD+H2O2
cytosol29.260.87No -
C’ GFP library in Starvation Media
cytosol27.30.81No -
C’ GFP library on the background of Pup2-DaMP

cytosol -
C’ GFP library on the background of CCT mutant

cytosol28.69460.857898No
